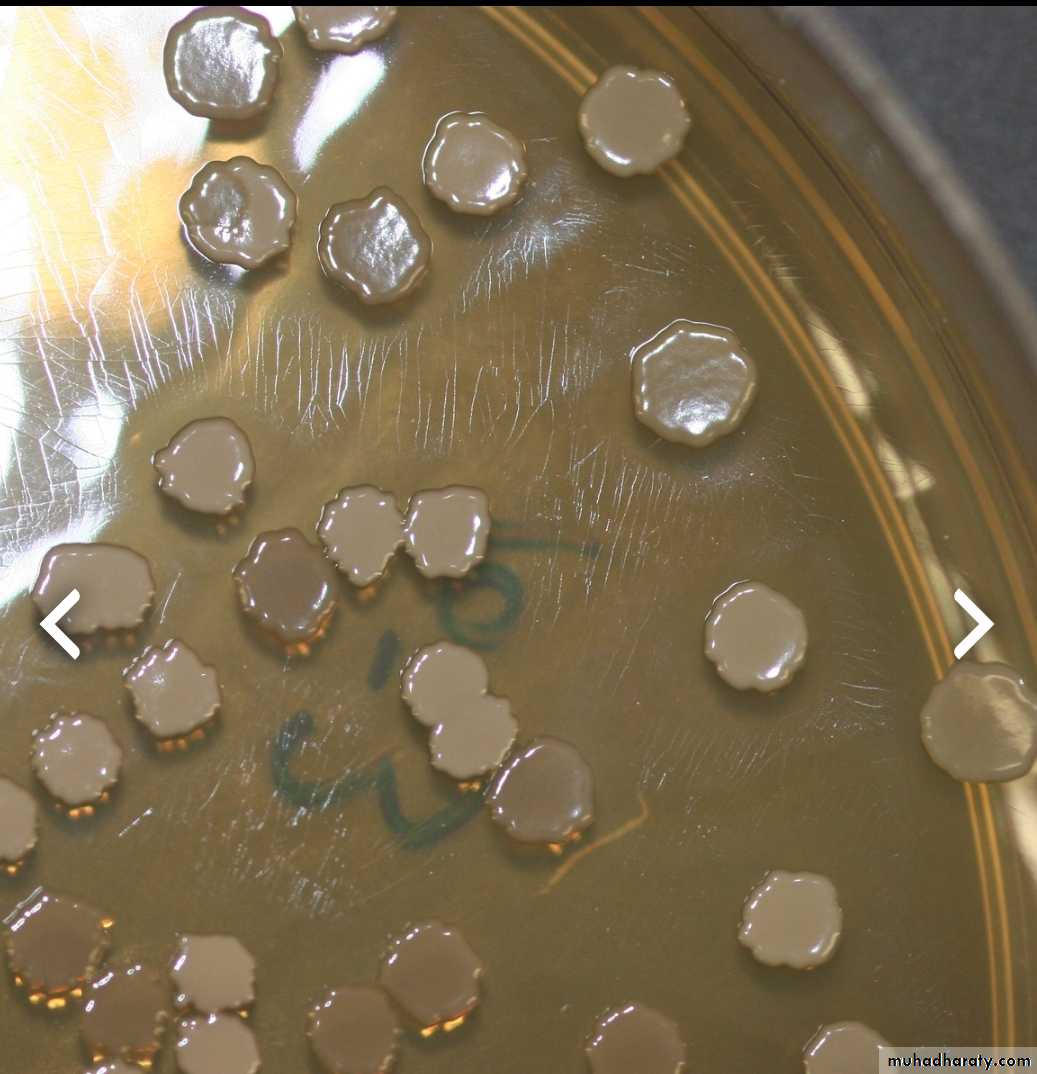
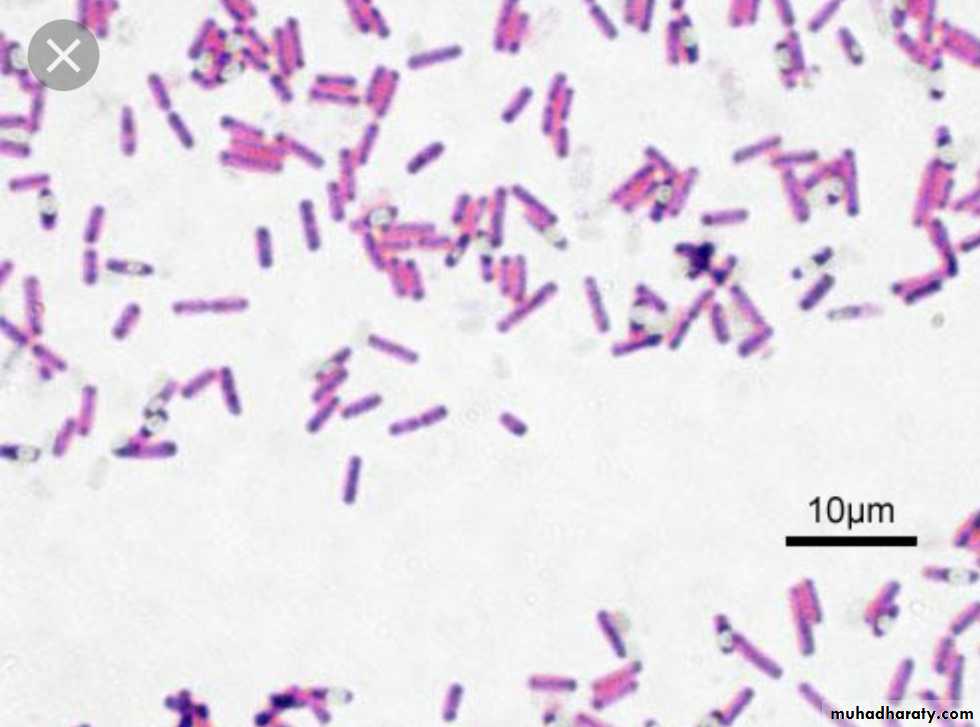

General Pathology of Infectious Diseases
Dr.Zahraa Osama YehyaDepartment of Pathology
Ninevah College of Medicine
Infectious Diseases
INTRODUCTIONDespite medical advances, only a handful of these diseases had actually been defeated, almost all victories are due to immunization programs (e.g. small pox, whooping cough, polio & measles), & thus, these diseases remain important cause of death around the globe, especially in developing countries due to the unsanitary living conditions & malnutrition
Although antibiotic usage has contributed indeed to the taming of some Infectious Diseases, indiscriminate use also has resulted in the development of increasingly virulent, multiple drug-resistant pathogens
The goal of these lectures is to highlight the general mechanisms by which infectious organelles cause pathology, i.e. to know the types, eatiology, pathogenesis, gross & microscopial appearance of these diseases so that we can understand the signs and symptoms, plan therapy, assess prognosis & plan prevention
Definition of infection
Infection is defined as the invasion of living tissue by m.o. or its products, followed by local reaction which may be associated with general reactionFollowing invasion, the m.o. may be :
eliminated without causing obvious disease (sub-clinical infection)or causing clinical disease of any grade of severity
The outcome depends on the complex balance between:the aggressive mechanisms of the m.o.
& the defense mechanisms of the host
Definitions
Commensalsare microorganisms that live on the expoure of the host WITHOUT causing harm. e.g. bacteria living on the skin, however, these harmless m.o. can cause diseases in case of immunodefeciency, these are called (Opportunistic infections)
Pathogen
m.o. that injure the host, this range from very small prion protein PPr which is 27 kD to 10 meters tape wormPathogenicity
the capacity of a particular m.o. to cause disease
Virulence
the degree of pathogenicityPrions
are modified host protein that can cause human disease like spongiform enchephalopathies as in Creutzfeld-Jacob disease (CJD-mad cow disease).Routes of Infection
InhalationIngestion
Sexual routes
Parentral e.g. injection , bite etc
transplacental
Factors influencing the infection
1- Microorganism factors• Access: entry of m.o to the body cells
2. Dose & virulence
3. Invasiveness: ability of m.o to multiply & spread in the body through the use of endotoxin & exotoxin
4. Transmission: ability of m.o to pass to another suitable host.
2-Host Factors:• Mechanical barriers: clean dry Intact skin, keratin, mucous membrane of the conjuctiva, respiratory & GIT epithelium.
• Chemical forces: acidity of sweat & gastric juice, lysosomal enz. secreted by mucous membrane of the lacrimal, salivary & nasal glands, secretory IgA antibodies in saliva, tears, intestinal contents, respiratory mucous, milk & urine.
• Physical Forces: movement of respiratory cilia, mucus, continuous flow of urine & saliva, increase peristalsis causing diarrhea .
• Phagocytosis: by macrophages & neutrophils.
• Specific immune response: by cell-mediated & humeral immunity.
• Local factors: e.g. ischemia & foreign body promote infection.
• Systemic factors: e.g., malnutrition, diabetes mellitus, chronic alcoholism & malignancy.• Age: both very young & very old have increasing risk of infection.
• Drugs: appropriate antimicrobial drugs eradicate many susceptible microorganism.
Results of infection
1. Eradication: most infections end by total eradication at the site of entry.2. Persistence of infection: either in form of carrier state or mild chronic forms e.g. typhoid fever, hepatitis infection.
3. Spread: to other parts of the body .e.g. direct spread as in cellulitis, lymphatic spread as in lymphangitis & lymphadenitis , blood spread as in bactermia, septicemia & pyaemia.
4. Host death: in severe infection e.g. tetanus & diphtheria.
Routs of infection spread inside the body1- Local spread: by the action of lytic enzymes. e.g Streptococci secrete hyaluronidase enzyme which degrades the extra cellular matrix between host cells.
2- Lymphatic spread: to the Lymph nodes.
3- Hematogenous spread: causing:-Bacteremia: Presence of m.o in the blood.
-Septicemia: actively multiplying m.o in the blood.
4- Through body fluids: e.g., sexual transmitted disease (gonococcus).
5- Through excretions: e.g., from kidney to lower urinary tract.6- Through nerves: e.g. rabies virus, varicella zoster virus.
7- Through placental- fetal route.
Tissue response ( microsopical responses) to infections
There are 5 major histological patterns of tissue reaction in infections:1- Suppurative ( PMN ) inflammation characterized by production of pus .
2- Mononuclear & Granulomatous characterized by interstitial inflammation & formation of granuloma
3- Cytopathic- Cytoproliferative inflammation. These reactions are usually produced by viruses.
4- Necrotizing inflammation caused by powerful toxins e.g. Cl. Perfringens lead to gangrene .
5- Chronic inflammation & scarring, is the final common pathway of many infections, e.g. HBV lead to cirrhosis, Schistosomal eggs lead to fibrosis of U.B. wall
techniques for diagnosis of infectious diseases
H&E stain: e.g. CMV & herpesviruse inclusion bodies, bacterial clumps, candida spp. All protozoa & helminthsGram stain: for most bacteria
Acid fast stain: for Mycobacteria
PAS (Periodic Acid Shiff): for fungi & ameobae, detect mucin & polysaccharides in m.o. cell wall
Silver stain: for fungi, pneumocystis
Giemsa stain: for Campylobacter, Leishmaniae, Malaria parasites
Culture: for all classes
Molecular diagnostic tests e.g. PCR
Viral Infections
Virusesare relatively simple, small, obligatory intracellular m.o. which replicates within cells by synthesis and assembly of separate components.
Viruses are classified by their nucleic acid genomes into:
DNA virusesRNA viruses
Routes of infection
Airborne: m.o. carried by air, direct contact is not needed e.g. measles virus.
Inhalation of respiratory droplets: direct contact is needed ; e.g. influenza, chicken pox, measles, pertusis, RSV.Ingestion : polio viruses
Parentral (s.c., i.v., i.m.) : e.g. AIDs in drug abuse & blood transfusion
Sexual route: e.g. HIV, HBV
Transplacental: e.g. HIV, HBV, HCV.
Following infection the virus is transmitted by blood cells, along nerves and become localized in certain tissue which it prefer (tropism) e.g. polio, rabies etc
Mechanisms of viral injury
1- Inhibits host cell DNA, RNA or protein synthesis e.g. Poliovirus.2- Direct cell killing by damaging host cell membrane or DNA e.g. Rhinoviruses.
3. Virus replicate efficiently causing host cell lysis e.g. rhinovirus & influenza4- Induce Immune reaction e.g type III & IV hypersensitivity reaction in respiratory cyncytial viruses, arbovirus encephalitis.
5- Damage host defence mechanism e.g. respiratory epithelium predisposes to the pneumonia by Staph. Pneumoniae & Haemophilus influenza. Immune system in AIDS.
6- Induce cell proliferation & transformation result in neoplasia e.g. HBV, EBV.
7- Virus killing cells of one type may cause damage to other cells that are dependent on the integrity of the virally damaged cells e.g. Poliovirus kills neurons leading to muscular atrophy.Microscopical picture of viral infection
Mononuclear infiltrationTissue necrosis
Giant cell formation
Inclusion body formation. (intranuclear or intracytoplasmic)
Giant cell pneumonia
Measles , RSV , para inlf. V.Multinuc. Giant cells
HSVViral inclusion bodies
viral particles aggregate within the cells they infect & form characteristic ( Inclusion bodies).Nuclear inclusions surrounded by a clear halo as in Herpes virus
Cytoplasmic inclusions as in small pox and rabies virusMany viruses do NOT give rise to inclusions e.g. EBV.
Perinuclear clearing & basophilic staining cytoplasmic inclusion bodies (owl’s eye appearance) CMV infection
Body response to viral infection
LymphocytosisProduction of interferons
Production of neutralizing a.b.s
Cell mediated immunity plays a role in controlling viral infection
Types of viral infection
Aborted.Latent : Virus is synthesized continuously without altered cell e.g. HBV.
Persistent: Integrated in the cells, reactivated with depressed immunity.Slow viral infection take very long incubation period as in HIV/AIDS.
Bacterial infectionsClassification of Bacteria
Bacteria are classified on several criteria:
Gram stain
Bacteria are accorodingly, of two types:Gram (+)
Gram (-)
Gram(+): e.g. Staph, Strept, Mycoplasma, Clostridium, Corynebac
Gram (-) Salmonella, Shigella, Pseudomonas, Neisseria, Klebsiella, H.pylori, E.coli
Shape
Bacteria are classified as:Cocci
Bacilli
Vibrios
Spirochates
Cocci : e.g. Strept, Staph
bacilli (rods) e.g.: Clostridium, Corynebac, Liisteria
• Vibrios e.g: V. cholerae
• Spirochetes e.g. Treponema pallidum (Syphlis)
Growth requirements
bacteria are classified as:Aerobic
Anaerobic
Mechanism of Bacterial injury(Pathogenesis)
1- Release toxins that kill cells. (exotoxin & endotoxin).2- Release lytic enzymes, includes proteases, hyaluronidase, coagulase & fibrinolysins that destroy the tissue & facilitate the spread of bacteria .
3- Elicit an inflammatory reaction that may destroy not only the bacteria but also the infected tissue.
4-Elicit an immune reaction that may damage the tissues carrying the same antigen as the bacterium (“cross reactivity”).